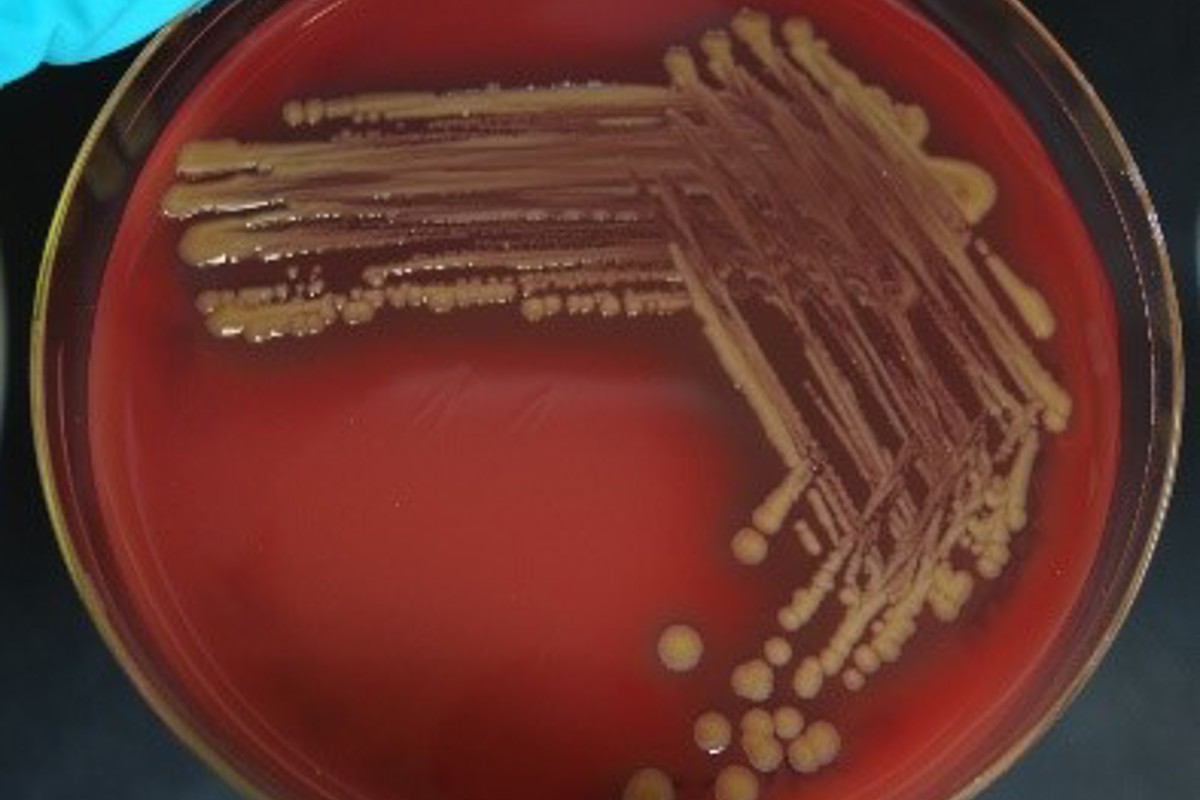

Fiskens hud, i tillegg til skjell og ytre slimlag, utgjør en viktig barriere mot det ytre miljø og beskytter fisken mot skadelige bakterier. Ved håndtering er det stor risiko for at huden skades, slim og skjell skrapes bort og det oppstår en innfallsport for bakterier. Skånsom håndtering, samt å unngå håndtering, spesielt ved fallende temperaturer, er viktig for å minimere risikoen for sårproblematikk.
Bakterielle sår kan skyldes en lokal infeksjon i huden eller en systemisk infeksjon med bakterier i blod og indre organer. For å kartlegge om det er en lokal infeksjon (f.eks. etter mekaniske skader eller manetangrep) eller om det er en systemisk infeksjon bør man ta ut prøver fra både sår og nyre til bakteriologisk undersøkelse.
Prøveuttak - Pharmaq Analytiq anbefaler analyse av to prøvetyper:
Ved sår i sjøvann gjøres det utstryk fra sår og nyre på blodagar med salt (BAS) og marinagar (MA). Blodagar med salt og vibriostat (BASV) kan også inkluderes. Prøveta gjerne opp til 5 affiserte fisk, for å sikre et godt prøvemateriale. Det blir valgt ut relevante kolonier fra innsendte skåler til videre analyse.
Tenacibaculum spp. vokser kun på MA, mens Moritella viscosa vokser på både BAS og MA. Begge disse bakteriene er saktevoksende og kan dø ved temperaturer over 12⁰C. For Moritella viscosa kan også BASV inkluderes. Dette mediet er tilsatt vibriostat som hemmer oppvekst av andre, mer rasktvoksende bakterier.
Generelt for alle medier anbefales 1-2 utstryk per skål, samt å sørge for god fortynning av utstrykene (Figur 1, Fortynning av utstryk og figur 2, overvekst av bakterier). Husk også å brenne av eller bytt podenål mellom fortynningsutstrykene.
Prøver bør holdes kjølige hele tiden – både Moritella og Tenacibaculum kan dø ved oppbevaring i romtemperatur. I tillegg risikerer man overvekst av bakterier på skålene. Oppbevaring i kjøleskap før forsendelse er helt prima! Ved innsending bør prøvene pakkes godt for å bevare kjøring under transport

Figur 1: Fortynning av utstryk. En prøve per skål og totrinns fortynning gjør det enklere og raskere å identifisere bakterier.

Figur 2: Overvekst av bakterier. For mange utstryk og tett vekst gjør det vanskelig å skille de ulike bakteriene fra hverandre og analysen på laboratoriet tar lenger tid.
Vevsprøver på MicrobeVision har begrenset holdbarhet og må sendes på raskest mulig måte. Det er svært viktig å sikre at prøvene er mottatt på laboratoriet innen 48-72 timer etter prøveuttak. Hvis dette ikke er mulig, er det bedre å så ut på skåler. Dette gjelder særlig for M. viscosa og Tenacibaculum spp.
Se uttaksveileder på vår hjemmeside, og video av prøvetakning i vår kundeportal iWISE.
Prøvene registreres elektronisk før innsendelse for en smidig og rask håndtering når de ankommer lab.
Har du spørsmål til prøveuttak eller bakterier kan du kontakte din kundekontakt, eller ansvarlig for mikrobiologi, Hege Hellberg.
PHARMAQ er verdens ledende selskap innen vaksiner og innovasjon rettet mot akvakulturnæringen og er en del av Zoetis, verdens ledende selskap innen dyrehelse. Våre innovative fiskehelseløsninger inkluderer et bredt spekter som fiskevaksiner, terapiprodukter, vaksinasjonsmaskiner inkludert servicetjenester, forskning og analyser. Selskapet leverer miljøvennlige, trygge og effektive helseprodukter til den globale akvakulturnæringen ved hjelp av målrettet forskning og engasjerte medarbeidere. Produksjon, administrasjon, forskning og utvikling ligger i Norge og med global virksomhet i kommersielle oppdrettsmarkeder har PHARMAQ rundt 375 medarbeidere. Konsernets produkter markedsføres i Europa, Nord- og Sør-Amerika samt i Asia. For mer informasjon, se selskapets hjemmeside: www.pharmaq.com. Personvernerklæring Erklæring om informasjonskapsler (cookies) Bruksvilkår
Copyright © 2020 Zoetis LLC. Alle rettigheter forbeholdt.